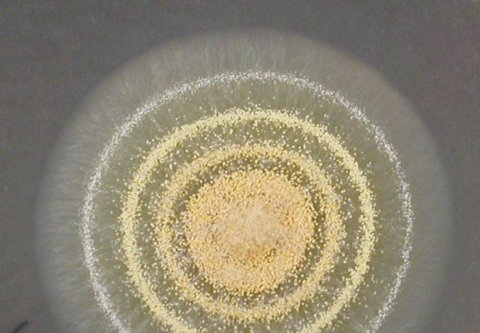

Schimmelpilze
Die ABIS GmbH führt bei Schimmelpilzbefall in Innenräumen Untersuchungen und Beratung durch. Auf Basis der Untersuchungsergebnisse und der Erkenntnisse der Ortsbegehung werden Empfehlungen zur weiteren Vorgehensweise und – sofern erforderlich – zur Sanierung ausgesprochen. Zur Ermittlung der Ursache für den Schimmelpilzbefall werden Messungen der Temperatur und Feuchtigkeit in der Raumluft und an den betroffenen Oberflächen durchgeführt.
Die Proben werden im eigenen Labor aufgearbeitet und ausgewertet. Die Probenahme und Untersuchung erfolgt nach den Vorgaben der VDI 4300-10 (Messen von Innenraumluftverunreinigungen - Messstrategien zum Nachweis von Schimmelpilzen im Innenraum) und der DIN EN ISO 16000-19 (Innenraumluftverunreinigungen - Teil 19: Probenahmestrategie für Schimmelpilze).
Folgende Untersuchungsmöglichkeiten bestehen:
- Beprobung von Oberflächen (z. B. Wand) ohne Zerstörung des Materials:
- Abklatsch-/Kontaktproben: Schimmelpilzsporen/-bestandteile werden von einer Oberfläche auf Nährböden übertragen. Nach 7 bis 10 Tagen Wachstumszeit werden die Proben ausgewertet.
- Klebefilmpräparate: Ein Klebefilm wird auf die zu untersuchende Oberfläche gedrückt und anschließend mikroskopiert. Es entfällt die Wachstumszeit für die Schimmelpilze
- Untersuchung von Materialproben durch direkte Mikroskopie oder Ansatz auf Nährböden. Dazu ist eine Entnahme des Materials erforderlich (z. B. Tapete, Estrichdämmung).
- Untersuchung der Raumluft – in Abhängigkeit der Fragestellung stehen zwei Methoden zur Verfügung:
- Partikelmessungen (Bestimmung der Gesamtsporenzahl). Die Proben werden mikroskopisch ausgewertet. Eine Auswertung kann zeitnah zur Probenahme erfolgen. Diese Methode wird vor allem dann angewendet, wenn der Erfolg einer Schimmelpilzsanierung überprüft werden soll.
- Luftkeimmessungen (Bestimmung der Lebendkeimzahl). Nach 7 bis 10 Tagen Wachstumszeit werden die Proben ausgewertet.



Schimmelpilze sind ein wesentlicher Bestandteil unserer Umwelt und Umgebung. Durch Lüften und durch Eintrag z. B. mit dem Schuhwerk befinden sich zahlreiche Schimmelpilzsporen natürlicherweise in unseren Innenräumen. Das ist ein normaler Zustand, an den das Immunsystem des Menschen angepasst ist. Erst beim Vorkommen von erhöhter Feuchtigkeit können diese Pilzsporen auskeimen und auf Baumaterialien und Inventar anwachsen. Bei einem Schimmelpilzbefall im Innenraum kann es in Abhängigkeit der Größe und Art sowie der Stelle des Befalls zu gesundheitlichen Beeinträchtigungen (z. B. Allergien, allgemeine Reizerscheinungen) beim Raumnutzer kommen.
Erhöhte Feuchtigkeit im Innenraum kann verschiedene Ursachen haben. Es kann sich u. a. um die Folgen einer Leckage an Rohrleitungen, von Undichtigkeiten in der Gebäudehülle wie z. B. im Dachbereich oder von anderen Bauschäden oder -mängeln handeln. Das Lüftungs- und Heizverhalten des Raumnutzers hat ebenfalls einen entscheidenden Einfluss auf das Raumklima und somit auf die Möglichkeit, dass Schimmelpilzbefall entstehen kann. In Neubauten kann ungenügend abgetrocknete Restfeuchte zu Schimmelpilzwachstum führen.
Die wichtigste Voraussetzung für eine erfolgreiche Sanierung ist die Ermittlung und Beseitigung der Ursache für die erhöhte Feuchtigkeit. Der Schimmelpilzbefall sollte fachgerecht entfernt werden und nicht einfach durch Desinfektionsmittel/Biozide abgetötet und/oder überstrichen werden. Auch abgetötete Pilzbestandteile wirken noch allergen und reizend.